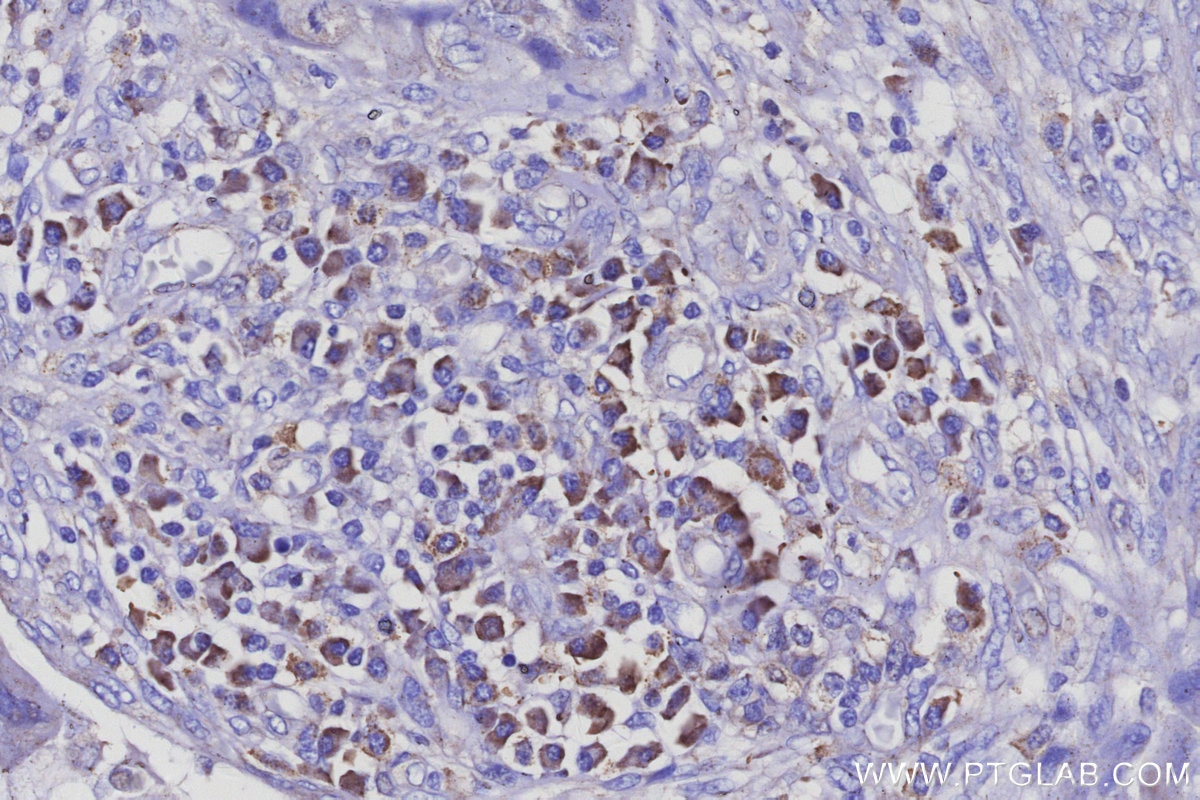

IHCeasy® AP3B1 Ready-To-Use IHC Kit
AP3B1 Ready-to-use reagent kit for IHC.
Cat no : KHC3134
Synonyms
Adaptor protein complex AP-3 subunit beta-1, Adaptor-related protein complex 3 subunit beta-1, ADTB3, ADTB3A, AP 3 complex subunit beta 1
Validation Data Gallery View All
Product Information
KHC3134 is a ready-to-use IHC kit for staining of AP3B1. The kit provides all reagents, from antigen retrieval to cover slip mounting, that require little to no diluting or handling prior to use. Simply apply the reagents to your sample slide according to the protocol and you're steps away from obtaining high-quality IHC data.
| Product name | IHCeasy® AP3B1 Ready-To-Use IHC Kit |
| Sample type | FFPE tissue |
| Assay type | Immunohistochemistry |
| Primary antibody type | Rabbit Polyclonal |
| Secondary antibody type | Polymer-HRP-Goat anti-Rabbit |
| Reactivity | Human |
Kit components
| Component | Size | Concentration |
|---|---|---|
| Antigen Retrieval Buffer | 100 mL | 50× |
| Washing Buffer | 100 mL ×2 | 20× |
| Blocking Buffer | 5 mL | RTU |
| Primary Antibody | 5 mL | RTU |
| Secondary Antibody | 5 mL | RTU |
| Chromogen Component A | 0.2 mL | RTU |
| Chromogen Component B | 4 mL | RTU |
| Signal Enhancer | 5 mL | RTU |
| Counter Staining Reagent | 5 mL | RTU |
| Mounting Media | 5 mL | RTU |
| Datasheet | 1 Copy | |
| Manual | 1 Copy |
Background Information
AP3B1 is the 140-kDa β3A subunit of the adaptor-related protein complex-3 (AP-3), a ubiquitous heterotetrameric complex that is localized to the trans-Golgi network and endosomes and is involved in protein trafficking to lysosomes or specialized endosomal-lysosomal organelles. This complex is composed of two larger subunits (δ and β3A or β3B), a medium subunit (μ3A or μ3B), and a small subunit (σ3A or σ3B). The absence of the β3A subunit (AP3B1) results in the loss of stability of AP3 and leads to degradation of μ3A, to which β3A is directly bound, while the other subunits are variably affected. AP3B1 contains three main domains: the N-terminal head domain, the hinge, and the C-terminal ear domain. It has been reported as a target of IP(7)-mediated pyrophosphorylation. Defects in AP3B1 are the cause of Hermansky-Pudlak syndrome type 2 (HPS2).
Properties
| Storage Instructions | All the reagents are stored at 2-8°C. The kit is stable for 6 months from the date of receipt. |
| Synonyms | Adaptor protein complex AP-3 subunit beta-1, Adaptor-related protein complex 3 subunit beta-1, ADTB3, ADTB3A, AP 3 complex subunit beta 1 |